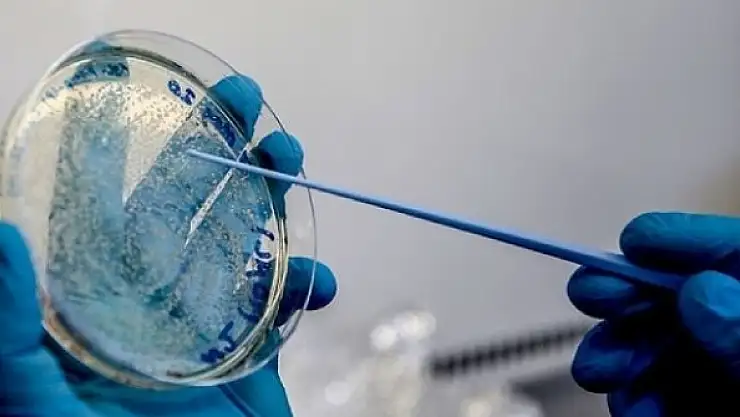

Avustralya ve Kanada'da Covid-19 aşı adayı insanlar üzerinde denendi
Avustralya ve Kanada'da geliştirilen iki Covid-19 aşı adayı insanlar üzerinde test edilmeye başlandı. 18 ila 55 yaşlarındaki deneklere ilk dozlar uygulandı.
"Clinicaltrialsarena.com" internet sitesinde yer alan haberlere göre, Avustralya'da Queensland Üniversitesi, Kanada'da biyolojik ilaç firması Medicago, Covid-19'a karşı bağışıklık sağlamayı amaçlayan aşı adaylarının birinci aşama klinik denemelerine başladı.
Avustralya'da Queensland Üniversitesi araştırmacılarının, İngiliz Milletler Topluluğu Bilimsel ve Endüstriyel Araştırma Kurumu (CSIRO) ve biyoteknoloji şirketi CSL ve ilaç şirketleri Patheon ve Cytiva işbirliğinde geliştirdiği aşı adayının testlerine, klinik hizmetler sağlayan Nucleus Network şirketinin Brisbane şehrindeki kliniğinde start verildi.
15-55 yaş aralığında uygulandı
18 ila 55 yaşlarındaki 120 sağlıklı gönüllünün katıldığı denemede deneklere ilk dozlar uygulandı.
Katılımcıların deney ve kontrol grubuna ayrıldıkları denemede deneylerin bir kısmına placebo niteliğinde etkisiz dozlar uygulanarak asıl aşının uygulandığı deneklerle karşılaştırma yapılacak.
Aşının güvenliğinin sınandığı birinci aşama denemenin üç ay içinde sonuçlandırılması hedefleniyor. Deneme başarılı olursa aşı ikinci aşamada daha geniş bir denek grubu üzerinde test edilecek.
Merkezi İngiltere'de bulunan Salgın Hastalıklara Hazırlık İçin Yenilik Koalisyonu (CEPI) ocak ayında Queensland Üniversitesi'ne Covid-19'a karşı bir acil müdahale aşısı geliştirmesi için 3,1 milyon dolar fon sağlamıştı.
Projeye, Queensland Eyalet yönetimi 6,9 milyon dolar, federal hükümet 3,4 milyon dolar, hayır kuruluşları ve diğer bağışçılar ise 10 milyon dolar mali katkı yaptı.
Avustralya'da bu ay başında Güney Avustralya eyaletinin başkenti Adelaide'da bir başka aşı adayı için klinik denemelere başlanmıştı.
Kanada'da bitki temelli bir aşı test edilmeye başlandı
Kanada'da ise ilaç firması Medicago ve biyoteknoloji şirketi Dynavax iş birliği ile geliştirdiği aşı adayı, Quebec eyaletinde insanlar üzerinde test edilmeye başlandı.
Aşı adayı, Medicago'nun bitkisel kaynaklardan ürettiği "Koronavirüs Benzeri Madde" (CoVLP) ile Dynavax'ın başka aşılarda da kullanılan "CpG 1018" adlı güçlendirici bileşeni içeriyor.
Güçlendirici bileşen, aşının ana maddesi olan antikor üreten antijenin bağışıklık etkisini arttırmayı hedefliyor.
18 ila 55 yaşları arasındaki 180 sağlıklı gönüllünün katıldığı birinci aşama denemede deneklere üç farklı dozda aşı uygulanacak.
Deneme aşının güvenliğinin yanı sıra, deneklerin doz toleransını ve aşı adayının bağışıklık etkisini değerlendirmeyi amaçlıyor.
Klinik denemeler 3 aşamada yapılıyor
Potansiyel bir aşının yaygın kullanılabilmesi için üç aşamada insanlar üzerinde test edilmesi gerekiyor. Birinci aşama klinik denemelerde az sayıdaki sağlıklı denek üzerinde aşının güvenli olup olmadığı ve olası yan etkileri araştırılıyor.
İkinci aşamada, güvenilirliği doğrulanan aşının etkinliği 100’den fazla denek üzerinde test ediliyor.
Üçüncü ve son aşamada ise aynı işlem, birkaç bin denekle tekrarlanıyor. Tüm bu süreç, aylar ve hatta yıllar alabiliyor.
23 aşının klinik denemeleri sürüyor
Dünya Sağlık Örgütü verilerine göre, 14 Temmuz itibarıyla Covid-19'a karşı 140 aşı adayı geliştirme, 23 aşı adayı ise klinik deneme safhasında bulunuyor.
Çin'de ortaya çıkan yeni tip koronavirüs (Covid-19) salgını 200'den fazla ülke ve bölgeye yayılarak salgına dönüştü. Dünya genelinde vaka sayısı 13 milyonu aşarken, 576 binden fazla kişi hayatını kaybetti.
Bakmadan Geçme